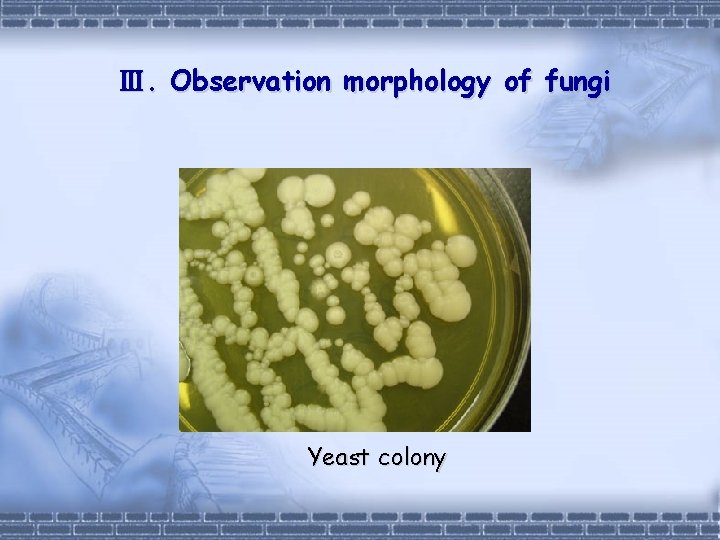
Ⅲ. Observation morphology of fungi Yeast colony
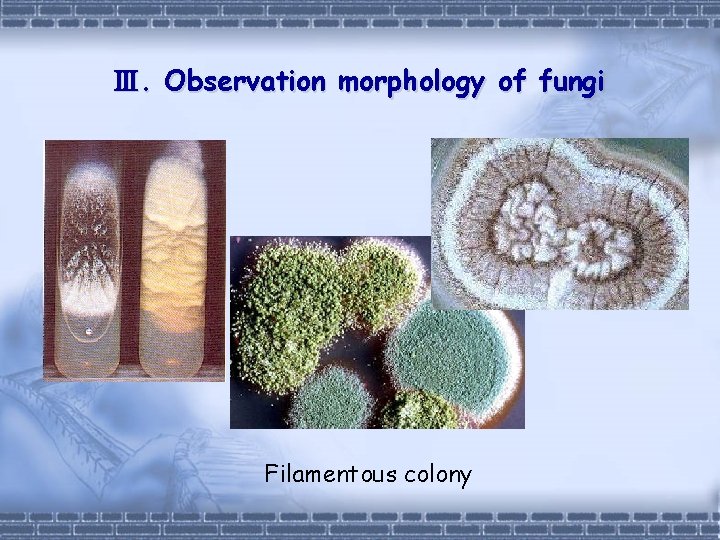
Ⅲ. Observation morphology of fungi Filamentous colony

Experiment 1 Hemagglutination test 2 Hemagglutination inhibition test

Experiment 1. Hemagglutination test 2. Hemagglutination inhibition test 3. Observation morphology of fungi

Ⅰ. Hemagglutination test Ø Principle: Some HA-bearing viruses agglutinate RBCs in vitro.

Ⅰ. Hemagglutination test Ø Procedures: discard 0. 25 ml Tubes 1 2 3 4 5 6 7 NS 0. 25 0. 25 virus 0. 25 (1: 4) (1: 8) (1: 16) (1: 32) (1: 64) (1: 128) (1: 256) 0. 5%RBC 0. 25 0. 25 (negative control) mix, RT, 45 min~1 hr,observation

Ⅰ. Hemagglutination test Ø Record the results

Ⅰ. Hemagglutination test Ø Interpretation Hemagglutination titer: is determined as the highest dilution of virus that can cause an obvious ( ++) hemaglutination. 1 2 (1: 8) 7(1: 16) (1: 256) ++++ 3 4 5 6 (1: 32) (1: 64) (1: 128) ++ ++ + - control

Ⅱ. Hemagglutination inhibition test Ø Principle: If a person is infected by HA-bearing virus, anti-HA Ab may appear in his serum. These antibodies can block hemagglutination and lead to the hemagglutination inhibition phenomenon.

Ⅱ. Hemagglutination inhibition test Ø Procedures: Discard 0. 25 ml Tube 1 2 3 4 5 6 7 NS(ml) 0. 45 0. 25 0. 45 serum 0. 05 0. 25 0. 05 (1: 10) (1: 20) (1: 40) (1: 80) Virus(4 U) 0. 25 0. 5% RBC 0. 5 0. 5 8 0. 25 (1: 160) (1: 320) Mix, RT, 1 hr, observation 0. 25 0. 5

Ⅱ. Hemagglutination inhibition test Ø Interpretation: Hemagglutination inhibition titer is determined as the highest dilution of serum that can completely inhibit hemagglutination.

Ⅱ. Hemagglutination inhibition test 1 8 1: 10 2 3 4 5 6 7 Acute phase 2 3 4 5 6 7 Convalescent phase 1: 20 1: 40 1: 80 1: 160 1: 320 - +

Ⅲ. Observation morphology of fungi Ø Observe colony morphology of three species of fungi Ø Observe morphology of fungi under a light microscope

Ⅲ. Observation morphology of fungi A. Observe colony morphology of three species of fungi 1. Sabouraud's agar plate culture of Cryptococcus neoformans --- yeast colony 2. Sabouraud's agar plate culture of Candida albicans --- yeast-like colony 3. Sabouraud's agar plate culture of mold --- filamentous colony
Ⅲ. Observation morphology of fungi Yeast colony
Ⅲ. Observation morphology of fungi Filamentous colony

Ⅲ. Observation morphology of fungi B. Observe morphology of fungi under a light microscope 1. India ink smear of Cryptococcus neoformans: capsules 2. Microcultures of Candida albicans: pseudohypha and chlamydospores 3. Microculture of mold: hypha and spores

Ⅲ. Observation morphology of fungi Cryptococcus neoformans

Ⅲ. Observation morphology of fungi Candida albicans

Ⅲ. Observation morphology of fungi
- Slides: 17